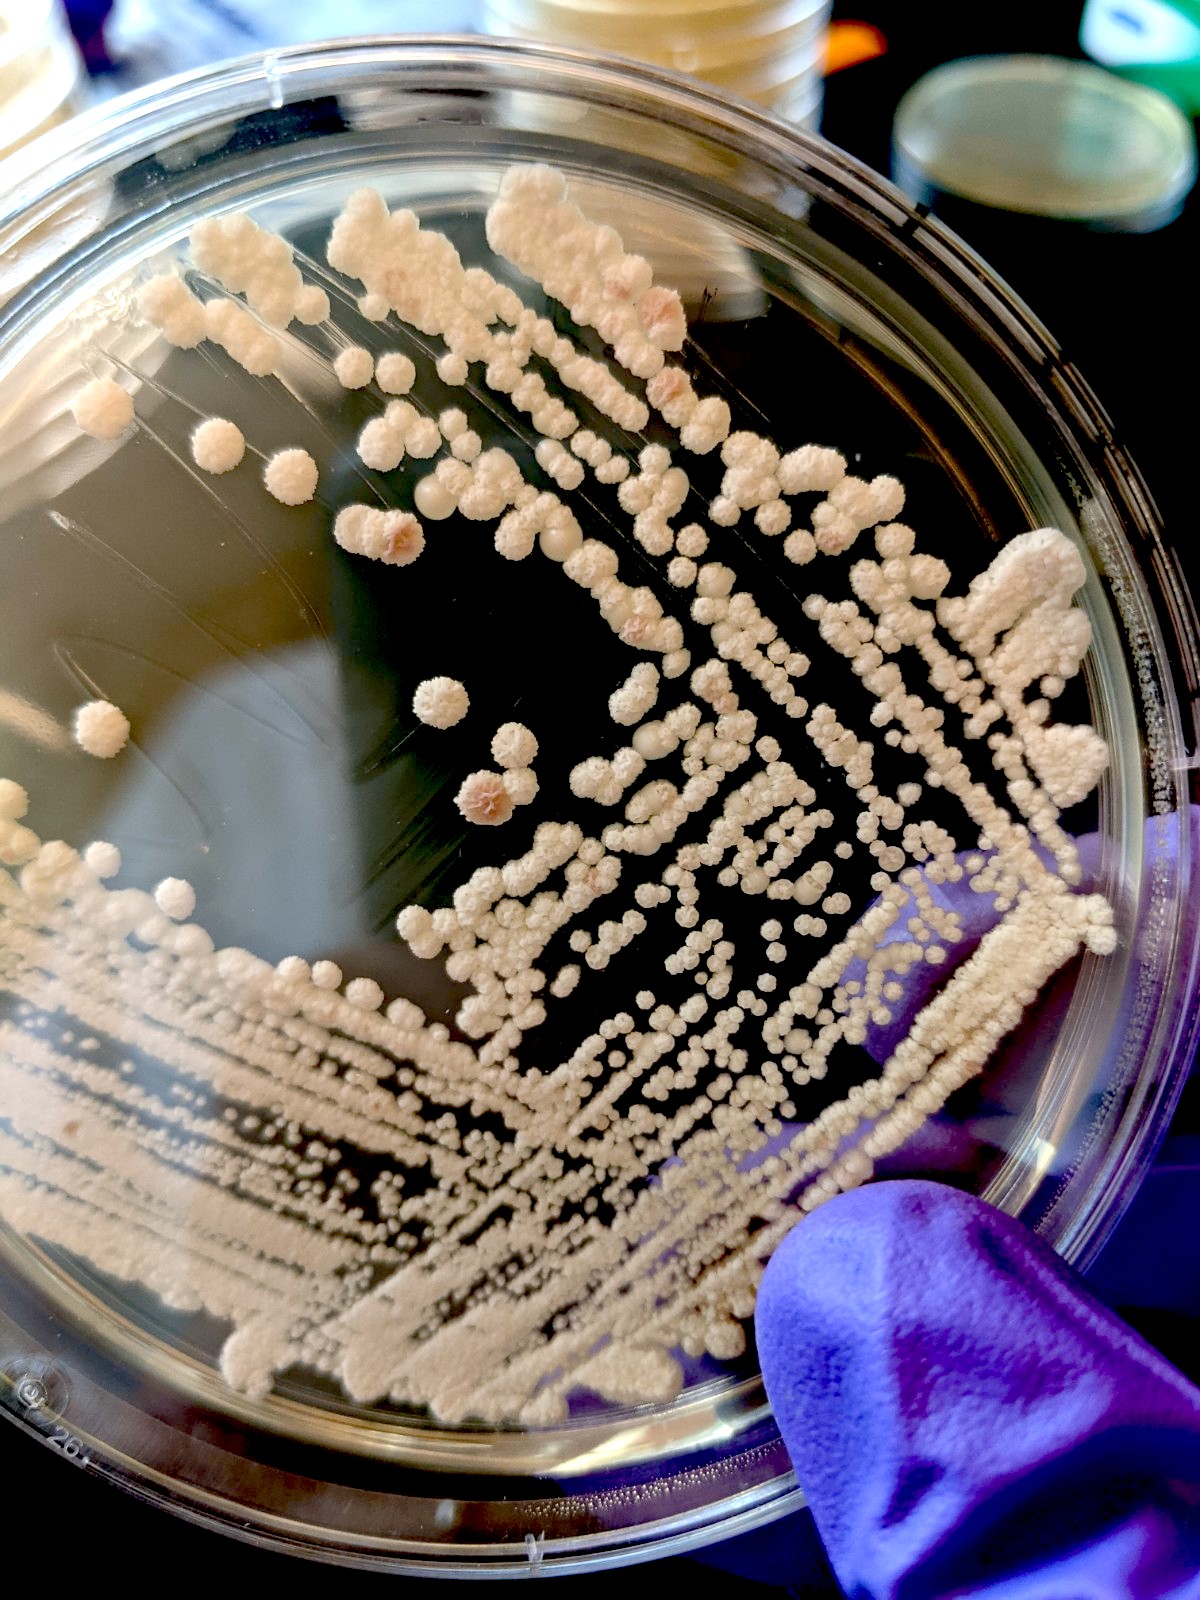
Probing the Eco-Evolutionary Dynamics&nbsp;of Microbial Systems

Biology Program Presents
Probing the Eco-Evolutionary Dynamics of Microbial Systems
Angela Oliverio, Syracuse University
Thursday, September 21, 2023
Reem-Kayden Center Laszlo Z. Bito '60 Auditorium
12:10 pm – 1:10 pm EDT/GMT-4
12:10 pm – 1:10 pm EDT/GMT-4
For more information, call 845-758-6822, or e-mail [email protected].
Time: 12:10 pm – 1:10 pm EDT/GMT-4
Location: Reem-Kayden Center Laszlo Z. Bito '60 Auditorium